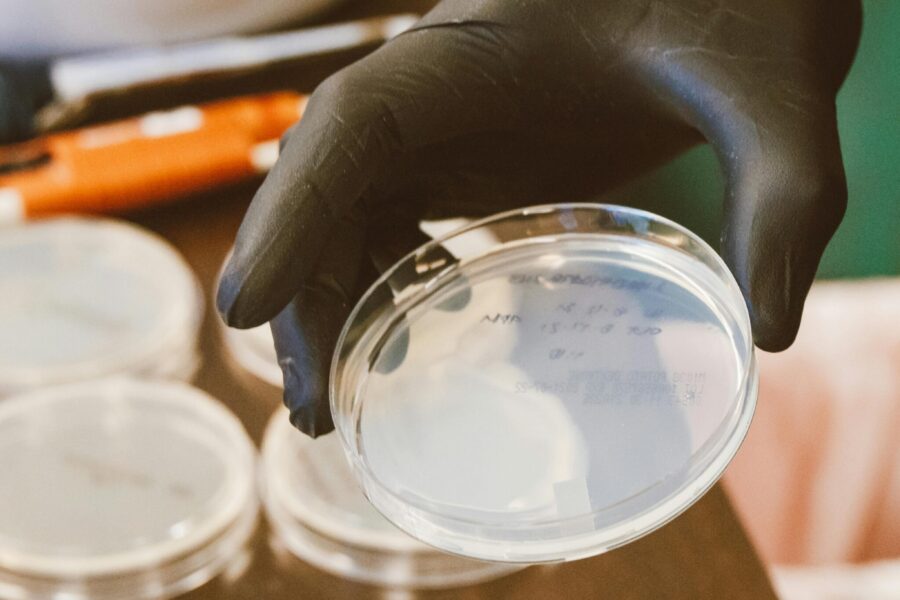
This photo shows a clinical setting and a hand with a glove holding a petry dish

Supporting and representing all local NHS General Practitioners
We champion, support, and represent GPs, practice managers, and practices across Kingston and Richmond, Croydon, Surrey, East Sussex and West Sussex - amplifying their voice, protecting their interests and strengthening their place at the heart of the NHS.
News headlines
Latest resources
Supporting GP practice to address inappropriate workload transfer and other non-contractual demands

Current vacancies in our area
Explore current General Practice vacancies in Kingston, Richmond, Croydon, Surrey, East Sussex, and West Sussex areas.